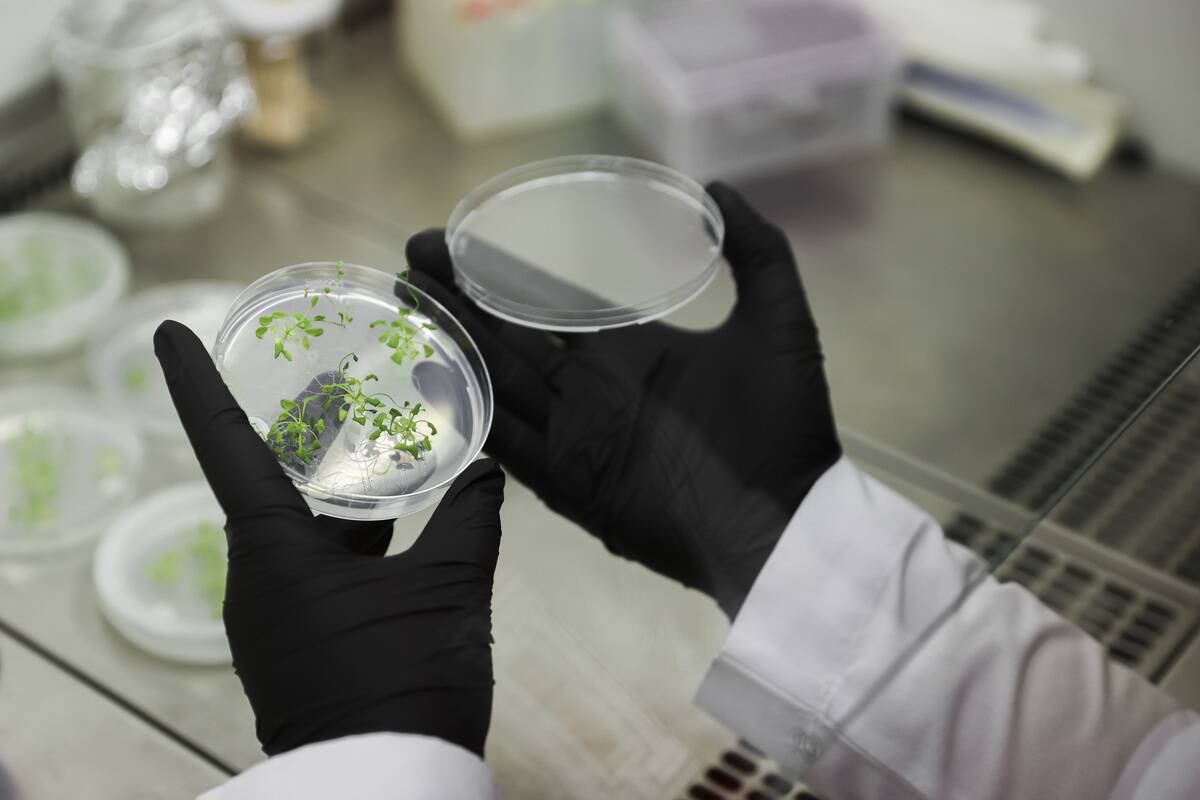
Researchers explore CRISPR gene editing on plants

How industrial chemicals alter cell signaling
Trending Now
Cellular communication is like a symphony being conducted within our bodies. Every cell chats with its neighbors, sharing essential information that keeps us healthy and functioning. This intricate network is crucial for processes like metabolism and immune response.
Imagine if these communications were disrupted—chaos would ensue! By understanding how cells talk, we can appreciate the marvel of our biology and the potential impacts of external threats on this delicate system.
Understanding the Basics of Cellular Communication

At its core, cellular communication involves cells sending and receiving signals through chemical messengers. These signals ensure that our body’s systems work in harmony. For instance, hormones are one type of messenger that travels through the bloodstream to target organs.
These interactions are precise, much like a well-rehearsed play where each actor knows their role. Disruptions in these signals can lead to diseases such as diabetes or cancer, highlighting the critical nature of maintaining cellular harmony.
A Quick Dive into Industrial Toxins

Industrial toxins are chemicals released into the environment through manufacturing and industrial processes. Common culprits include lead, mercury, and asbestos. These substances can infiltrate air, water, and soil, eventually finding their way into our bodies.
Their presence in the environment is an unfortunate byproduct of industrialization, raising concerns about their long-term effects on health. Identifying and understanding these toxins is the first step toward mitigating their harmful impact.
The Invisible Threat: How Industrial Toxins Operate

Industrial toxins might not be visible, but their effects are profound. Once in the body, they can alter cellular functions by binding to proteins or disrupting DNA. For example, heavy metals like lead can mimic essential minerals, interfering with normal cellular processes.
This invisible threat operates silently, often going unnoticed until significant damage has occurred. Awareness and monitoring of these toxins are crucial for preventing their insidious impact.
Cellular Communication: The Body’s Natural Network

Think of cellular communication as the body’s own internet, where messages are sent, received, and processed at lightning speed. This network enables cells to respond to external stimuli and coordinate actions like healing wounds or fighting infections.
Unlike digital networks, cellular communication relies on biochemical signals, which are incredibly efficient and precise. This natural network is vital for survival, underscoring the importance of protecting it from disruptions.
How Industrial Toxins Disrupt Cellular Harmony

When industrial toxins invade the body, they can throw the cellular communication network into disarray. These toxins might block receptors or interfere with signal transduction pathways, leading to miscommunication between cells.
For instance, endocrine disruptors can mimic hormones, causing cells to respond inappropriately. This disruption can result in a range of health issues, from developmental problems to chronic diseases, emphasizing the need for vigilance and protective measures.
The Science Behind Cellular Communication Breakdown

Research has shown that toxins can cause cellular communication breakdown by altering gene expression or damaging cellular structures. For example, exposure to certain chemicals can lead to oxidative stress, which harms cell membranes and hinders signal transmission.
Scientists use sophisticated techniques like molecular imaging to study these disruptions, aiming to develop strategies to counteract or prevent them. Understanding the science behind these breakdowns is key to developing effective interventions.
Spotting the Culprits: Common Industrial Toxins

Some of the most notorious industrial toxins include polychlorinated biphenyls (PCBs), benzene, and formaldehyde. PCBs, used in electrical equipment, are persistent in the environment and can accumulate in the food chain.
Benzene, found in petroleum products, is known for its carcinogenic properties. Formaldehyde, used in building materials, can cause respiratory issues. Identifying these culprits allows for targeted measures to reduce exposure and protect public health.
Real-Life Examples of Toxin-Induced Cellular Miscommunication

One real-life example of toxin-induced miscommunication is Minamata disease, caused by methylmercury poisoning in Japan. Mercury interfered with cellular functions, leading to severe neurological symptoms.
Another example is asbestos exposure, which disrupts cellular repair mechanisms and can result in lung cancer. These cases highlight the devastating effects of toxin-induced cellular miscommunication and the importance of stringent regulations to prevent similar incidents in the future.
The Role of the Environment: Amplifying the Impact of Toxins

The environment plays a significant role in amplifying the impact of industrial toxins. Factors such as climate change and pollution can increase the concentration and spread of these substances.
For instance, warmer temperatures can enhance the volatilization of certain chemicals, making them more prevalent in the air. Additionally, ecosystems can become reservoirs for toxins, further exposing wildlife and humans. Understanding these environmental dynamics is essential for effective toxin management.
The Domino Effect: How One Toxin Can Affect the Entire System

The introduction of a single toxin into the body can trigger a domino effect, affecting multiple systems. For example, lead exposure can impair brain development, which in turn affects cognitive functions and behavior.
This can lead to a cascade of health issues, demonstrating how interconnected our body’s systems are. Preventing the initial exposure to toxins can stop this domino effect, preserving the integrity of the entire biological network.
The Body’s Defense Mechanisms Against Industrial Toxins

Our bodies are equipped with defense mechanisms to combat industrial toxins. The liver plays a crucial role by metabolizing and detoxifying harmful substances. Enzymes like cytochrome P450 help process and eliminate toxins.
Additionally, the immune system detects and neutralizes foreign invaders, including toxic chemicals. Despite these defenses, the sheer volume and variety of industrial toxins can overwhelm the body, highlighting the need for reducing exposure and enhancing protective measures.
Innovative Research: Tracking Cellular Communication Changes
Innovative research is underway to track changes in cellular communication caused by toxins. Scientists are developing advanced biomarkers to detect early signs of disruption. Technologies like CRISPR and RNA sequencing allow researchers to study gene expression changes in response to toxin exposure.
These advancements hold promise for early detection and intervention, potentially preventing the progression of toxin-related diseases. As research evolves, so do the strategies to safeguard cellular communication.
The Surprising Sources of Industrial Toxins in Daily Life

Industrial toxins can be found in everyday items we might not expect. Household products like cleaning agents, cosmetics, and even furniture can contain harmful chemicals. For example, phthalates in plastics and parabens in cosmetics are common offenders.
Awareness of these sources can help individuals make informed choices to reduce exposure. By opting for eco-friendly products and checking labels, we can minimize the presence of toxins in our daily lives.
How Lifestyle Choices Can Minimize Toxin Exposure

Simple lifestyle choices can significantly reduce exposure to industrial toxins. Eating organic foods, using natural cleaning products, and avoiding processed items can limit intake of harmful chemicals. Regular exercise and hydration also support the body’s detoxification processes.
By being mindful of our environment and consumption habits, we can protect ourselves from the adverse effects of toxins. Small changes in daily routines can lead to a healthier, toxin-free life.
The Future of Cellular Communication Research

The future of cellular communication research is bright, with exciting developments on the horizon. Advances in nanotechnology and artificial intelligence are paving the way for more precise monitoring of cellular processes.
These technologies could lead to personalized medicine approaches, tailoring treatments based on individual cellular communication patterns. As our understanding deepens, we are better equipped to address the challenges posed by industrial toxins and protect human health.
Steps Towards a Toxin-Free Environment

Creating a toxin-free environment requires concerted efforts from governments, industries, and individuals. Implementing stricter regulations on chemical emissions and promoting sustainable practices are crucial steps.
Industries can adopt cleaner technologies to reduce toxin release, while individuals can advocate for greener policies. By working together, we can reduce the prevalence of industrial toxins and create a healthier environment for future generations.